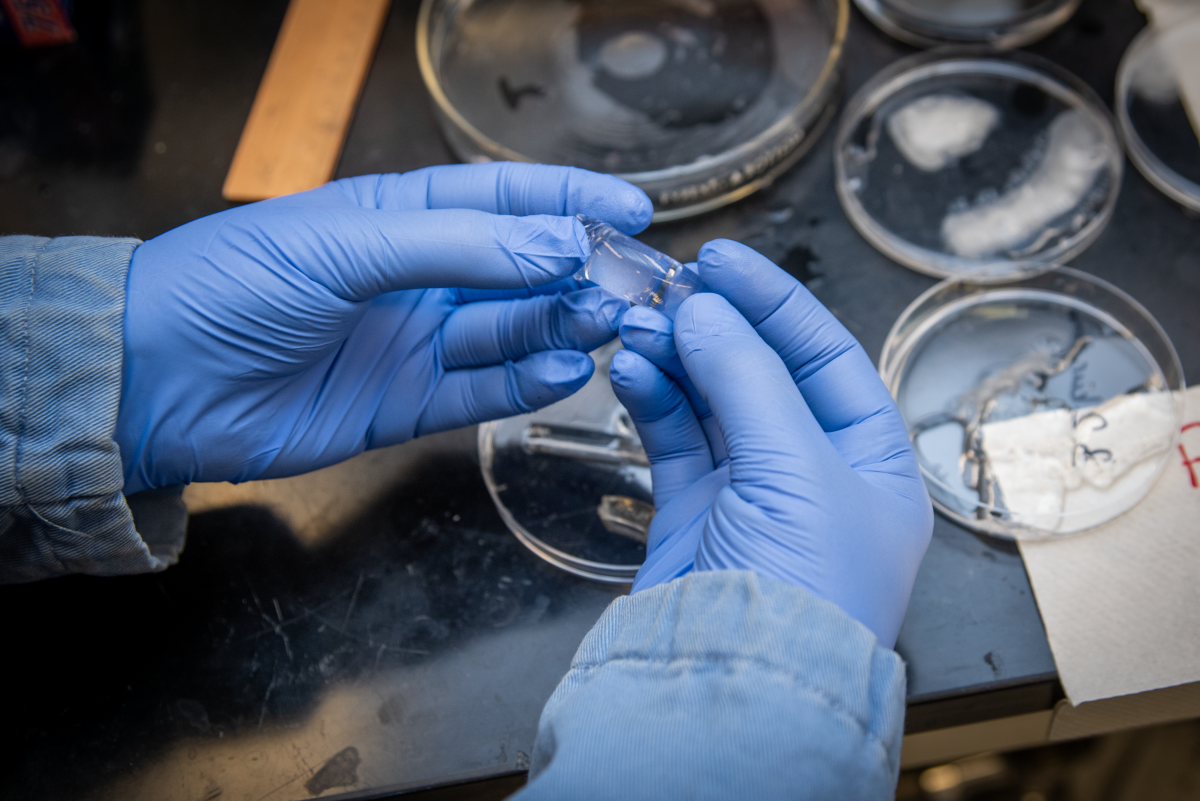
Gao Liu Lab

Our Research & Lab Websites
We maintain many websites to provide information for policymakers, industry partners, the public and government entities. Below is a list of all of our websites and what they do.
Battery Research Group
The Battery Research Group conducts renowned fundamental and applied research that has led to a deep understanding of electrochemical processes and the discovery of the next generation of battery materials and materials processing.
Energy Conversion Group 
The Energy Conversion Group focuses on a diverse portfolio of advanced energy conversion technologies with the goal of providing the tools necessary to create and sustain energy systems. Our group is a multidisciplinary team of electrochemists, chemical engineers, mechanical engineers, theorists and material scientists.
Energy Storage
The Energy Technologies and Systems Division (ETS) brings together multiple facets of energy technology and systems work, not only within the division but also throughout the Lab. Capabilities include synthesis, polymer science, characterization, theory and modeling, as well as building, testing, and evaluation. Current and developing opportunities and contractual mechanisms to work with ETS and Berkeley Lab researchers are available for many types of projects.
Grid Integration Group
The Grid Integration Group studies the infrastructure that is compatible with requirements of electric system grid operators and electric utility companies while serving the loads and needs of electricity customers.
Hacking Materials Research Group 
The Hacking Materials Group leverages advances in theoretical materials science, supercomputing, and informatics to understand and design new materials for energy applications. We work closely with experimental groups to bring materials from the computer to the laboratory.
Hydrogen Research at Berkeley Lab
Learn about Berkeley Lab's leadership role in hydrogen research, across both fundamental science and applied technologies.
Kostecki Lab
Robert Kostecki’s group conducts research on basic processes and fundamental phenomena that occur in electrical energy storage/conversion devices and water treatment systems.
Kusoglu Lab Research 
Kusoglu Lab Research involves a wide range of topics from modeling and diagnostics of ion-containing polymers (ionomers) and thin films at electrode interfaces, including interrogation of their transport and mechanical properties and structure/function relationships, to morphological characterization through state-of-the-art synchrotron X-ray techniques at the Advanced Light Source (ALS).
Laser Technologies Group 
The Laser Technologies Group works to develop the next-generation of novel laser sensors for identifying the chemical makeup of materials in real-time. Applications include energy storage (batteries), energy conversion, biology, environment and nuclear security.
Million Mile Fuel Cell Truck (M2FCT) 
Million Mile Fuel Cell Truck (M2FCT) is a Department of Energy (DOE)-funded consortium formed by five primary national labs to overcome durability challenges in proton-exchange membrane fuel-cells for heavy-duty applications with an initial focus on long-haul trucks.
Gao Liu Research Group
Gao Liu Research Group combines synthetic chemistry, composite engineering, and electrochemistry to solve the interdisciplinary problems in energy generation, storage, and usage.
Persson Group 
The Persson Group studies the physics and chemistry of materials using atomistic computational methods and high-performance computing technology.
Thermal Energy Group 
The Thermal Energy Group is a science-to-systems lab conducting research in manipulating matter at nanoscale dimensions for novel applications in a multitude of thermal and electrochemical energy devices and systems.
Tucker Research Lab 
Tucker Research Lab develops electrochemical devices at all stages from inception to product prototyping. We focus on devices with ceramic active materials, including solid oxide fuel cells and electrolysis cells, and solid state batteries.
Weber Research Group 
The Weber Research Group explores electrochemical-based energy-conversion materials and assemblies across various technological platforms and applications. We conduct fundamental research on applied problems, with work focused mainly on exploration of transport phenomena.